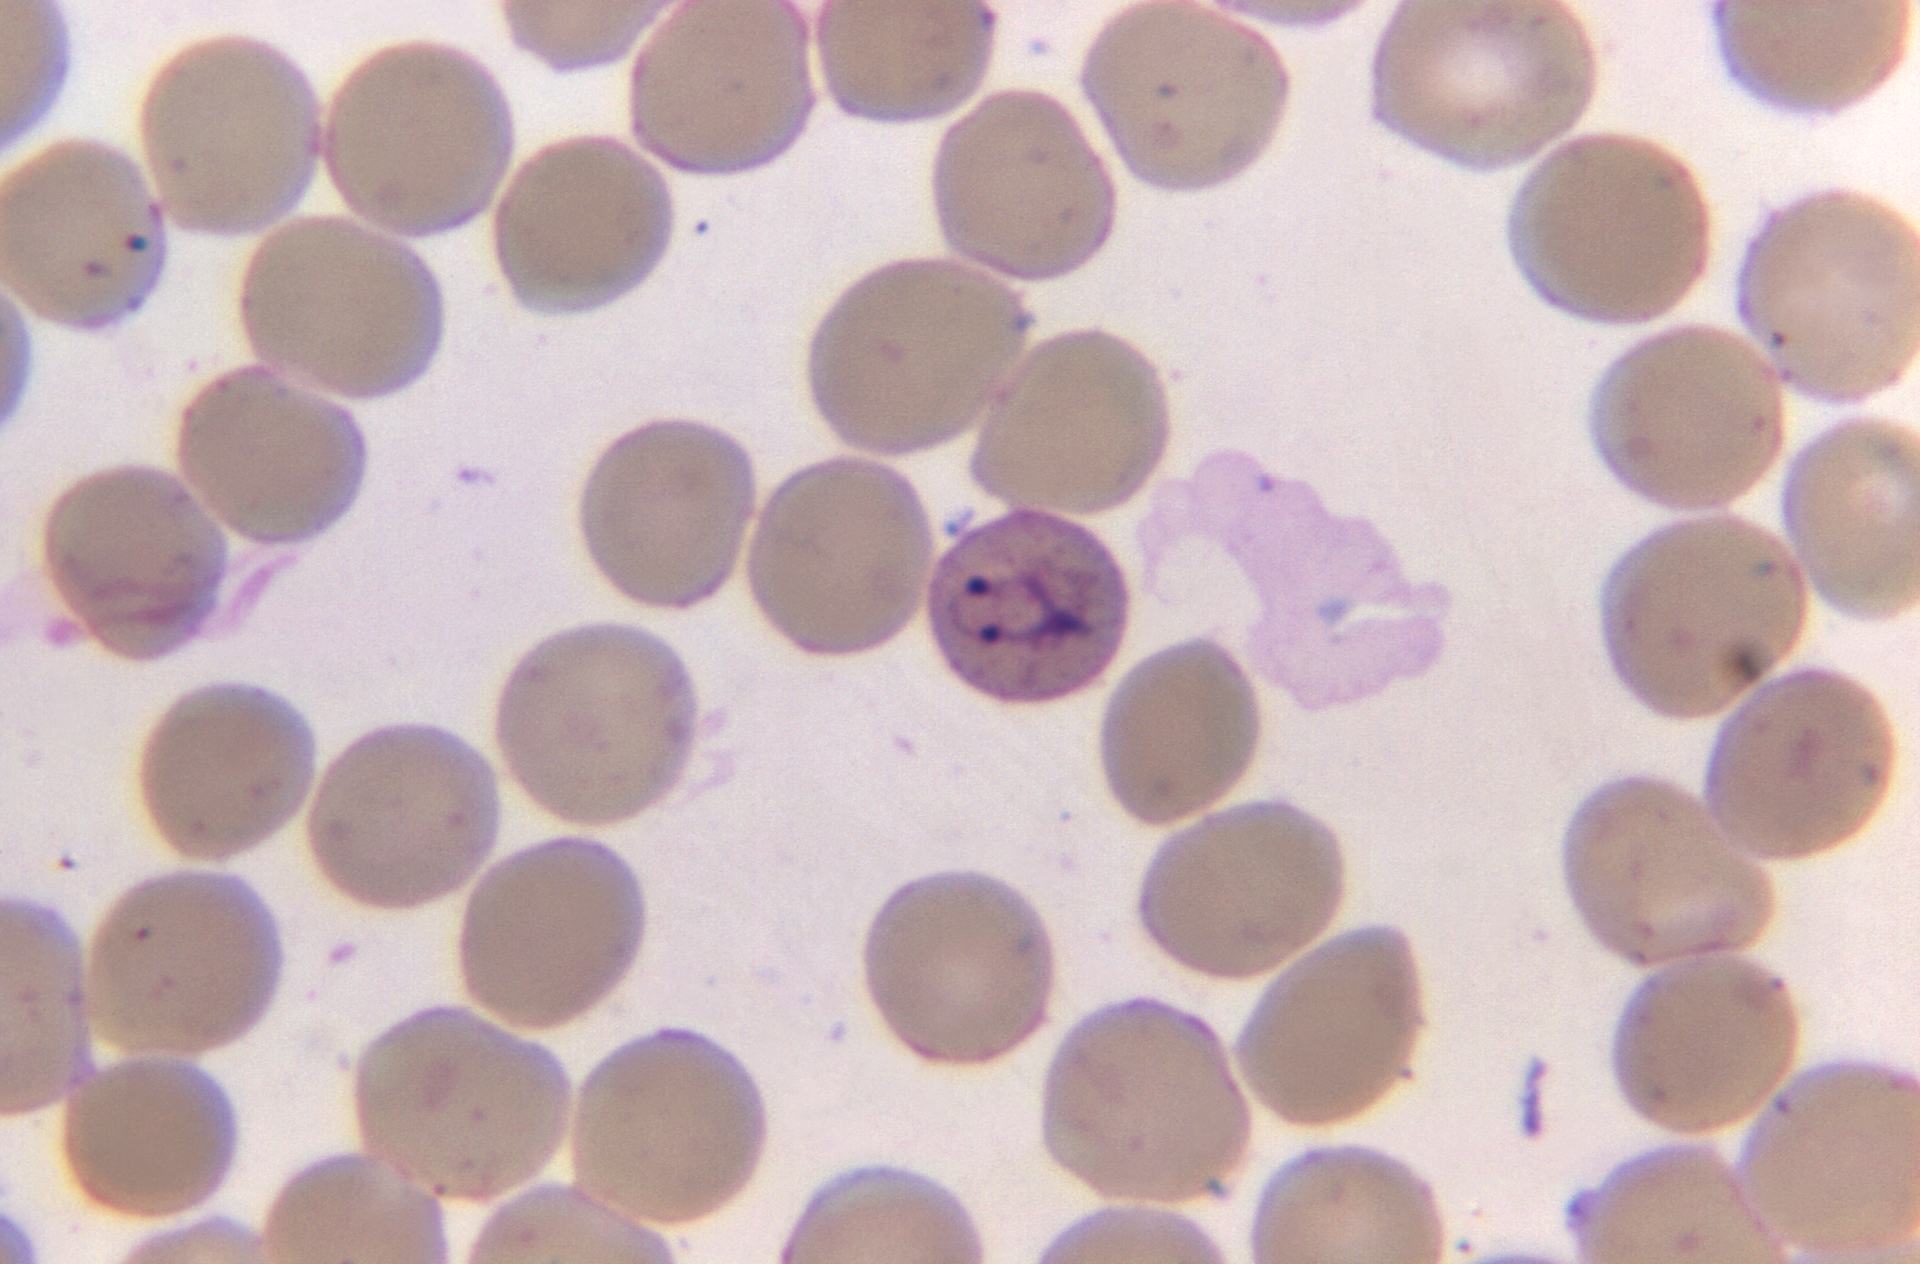
Courtesy of CDC

WHO recommends widespread malaria vaccinations for at-risk children
The World Health Organization (WHO) is recommending widespread use of the RTS,S/AS01 (RTS,S) malaria vaccine among children in sub-Saharan Africa and in other regions with moderate to high P. falciparum malaria transmission according to their report.
The recommendation is based on results from an ongoing pilot programme in Ghana, Kenya and Malawi that has reached more than 800 000 children since 2019.
Malaria remains a primary cause of childhood illness and death in sub-Saharan Africa. More than 260 000 African children under the age of five die from malaria annually. In recent years, WHO and its partners have been reporting a stagnation in progress against the deadly disease.
"For centuries, malaria has stalked sub-Saharan Africa, causing immense personal suffering,” “We have long hoped for an effective malaria vaccine and now for the first time ever, we have such a vaccine recommended for widespread use. Today’s recommendation offers a glimmer of hope for the continent which shoulders the heaviest burden of the disease and we expect many more African children to be protected from malaria and grow into healthy adults,” said Dr Matshidiso Moeti, WHO Regional Director for Africa.
Next steps for the WHO-recommended malaria vaccine will include funding decisions from the global health community for broader rollout, and country decision-making on whether to adopt the vaccine as part of national malaria control strategies.